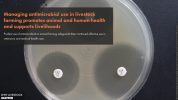

Managing antimicrobial use in livestock farming promotes animal and human health and supports livelihoods
Prudent use of antimicrobials in animal farming safeguards their continued effective use in veterinary and medical health care.
Core message
Facts
- Antimicrobial resistance is one of the top ten most urgent global health challenges.
- 700,000 people die every year from formerly treatable infections caused by bacteria, viruses, fungi and parasites that have developed resistance to antimicrobial drugs.
- If no action is taken, drug-resistant infections could cause 10 million deaths a year by 2050.
- Livestock production is the largest global consumer of antimicrobials and aquaculture is another significant consumer.
- Antimicrobial drug use in farmed animals is growing fastest in low and middle income countries.
- Global livestock output could fall by more than 11% with the rise of antimicrobial resistance.
- By 2030, shocks due to antimicrobial resistance could cost the world up to USD3.4 trillion a year and force an additional 24 million people into extreme poverty.
Antibiotics and other antimicrobial drugs have been fantastically effective treatments for people and animals for nearly a century. Ironically, it is their use—and sometimes misuse—that has helped bacteria and other disease-causing agents (pathogens) to evolve resistance to them.
A post-antibiotic era would be disastrous for livestock farming in addition to public health.
Like people, livestock would die of common, once-treatable infections. People working with livestock would be at particular risk of becoming ill with infections resistant to treatment as a result of their close contact with infected animals. Others would also increasingly be indirectly infected with drug-resistant microbes through consuming infected meat, milk and eggs (in addition to expected higher exposure to ineffective human drugs).
The misuse of antimicrobials in livestock production also eventually leads to more disease in the animals they are intended to benefit, with resulting livelihood impacts for livestock keepers.
The rise of antimicrobial resistance (AMR) is fuelled largely by the overuse and misuse of antibiotics and other antimicrobial drugs in human medicine. However, Yet misuse of such drugs is now increasing in livestock production, particularly as livestock production intensifies.
Environmental contamination
Land, water sources and even air can become contaminated with drug-resistant microbes via manure and other by-products of farming (see section Health - Integrating livestock and environmental planning can stem disease outbreaks). Drug-resistant microbes can subsequently find their way to people and animals via crops, fruit and vegetables grown in contaminated environments.
The precise contribution of antimicrobial use in livestock production to the on-going spread of AMR in people and the environment is unclear. It is hard to assess because the same antimicrobials are used in human and animal health care. However, ending misuse of antimicrobials in livestock farming and aquaculture is imperative to safeguard future human as well as animal health.
Controlling the spread of AMR requires prudent and safe use of antimicrobials in both people and animals. Safeguards are also needed to prevent AMR transmission through food chains or the environment. One Health approaches that consider the whole system and tackle the various ‘hot spots’ from public health, veterinary, environmental and food safety perspectives are most likely to achieve this.
What can be done
Promote rational and equitable use of antimicrobials
- Support evidence-based treatment decisions in livestock farming and aquaculture as well as in human health.
- Invest in public awareness campaigns that help improve the managed use of antimicrobial and end its misuse.
- At the same time, farmers should be provided adequate access to veterinary services, particularly in the poorer countries where controlled access to vital antimicrobial drugs are needed to treat sick animals.
Support alternative paths to health
- Support better animal husbandry practices, including vaccination campaigns and other alternatives to antimicrobial use.
- Support better human health services. In particular, improved sanitation and access to safer food (see section Health - Healthy, well cared for livestock contribute to improved animal, human and environmental health) and clean drinking water will do much to stem the rise of AMR in medical care.
Control and monitor farm effluents
- Help reduce drug-resistant pathogens in farm effluents and manure to prevent contamination of water sources, soils and crops.
- Support surveillance and diagnostics work needed to monitor levels of resistant microbes and to identify where action is needed.
Support sector collaboration
- Support governments to implement their national AMR action plans and promote inclusion of both private sector and the informal sectors.
- Encourage work across all sectors and between all sectors when implementing antimicrobial regulations and policies.